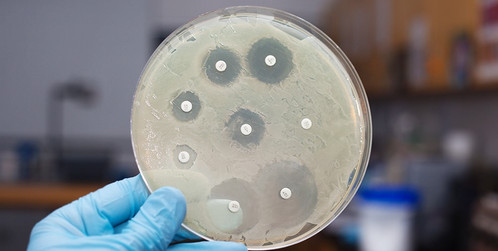

Cite 3 estruturas obrigatórias(fundamentais) e não-obrigatórias(acessórias) nas bactérias.
Fundamentais: parede celular, membrana plasmática e cromossomo.
Acessórias: flagelo, plasmídeo e cápsula.

Sobre a presença de micro-organismos residentes pelo nosso corpo, fale sobre algumas vantagens e as desvantagens dessa simbiose.
Cite os componentes que constituem a parede celular dos fungos.

Mananas, glicanas e quitina (sem peptídeoglicano).

Quais as principais estruturas virais?
Capsídeo, capsômero, ácido nucléico e envelope.
Cite características principais dos fungos fitopatogênicos.
Causam a maioria das doenças em plantas; são parasitas obrigatórios e facultativos; causa danos na parte área, radicular e sistêmica; diminui a produtividade e afeta a qualidade dos produtos;
Um estudante de biologia está sentindo um inchaço com vermelhidão na sua coxa esquerda. Sabe-se que é um furúnculo causado por um conjunto de bactérias esféricas organizadas em cachos, pertencendo a microbiota da pele, sendo oportunista e piogênica. Qual espécie seria a provável encontrada na coleta desse material?
a) Bacillus spp
b) Streptococcus pyogenes
c) Staphylococcus aureus
d) Mycobacterium tuberculosis
c) Staphylococcus aureus

Explique o por quê da frase "as células bacterianas em autoclave morrem por oxidação dos seus componentes, já que o calor é do tipo seco é mais penetrante, e em estufa, por desnaturação das proteínas de membrana, já que o calor é umido e menos penetrante" está errada.
Porque o mecanismo de ação da autoclave é por calor úmido, provocando desnaturação das proteínas na célula bacteriana.

Qual a finalidade dos esporos fungicos?

Reprodução sexuada e assexuada.
Sabendo que o vírus possui uma morfologia variada, quais as simetrias que podem apresentar?

Como ocorre o processo infeccioso na relação patógeno-hospedeiro?
Primario: introduz o patógeno a planta atuando como saprobio ou forma de resistência;
Secundario: após a multiplicação, dissemina-se para as demais plantas
Sobre a coloração de Ziehl-Neelsen marque a alternativa correta:
a) É uma importante coloração na bacteriologia, pois permite a visualização de todas as bactérias, positivas e negativas.
b) É uma técnica de pré-coloração para poder utilizar a Coloração de Gram.
c) É uma técnica utilizada para identificar bactérias que são bem menores e que não podem ser coradas pela Coloração de Gram, como as Mycobacterium spp.
d) É uma técnica simples, sendo utilizado apenas o cristal violeta e a fucsina acida.
c) É uma técnica utilizada para identificar bactérias que são bem menores e que não podem ser coradas pela Coloração de Gram, como as Mycobacterium spp.

Sabendo sobre os mecanismos de resistência a antibióticos, defina o que são plasmídeos.
Plasmídios são porções do DNA extracromossomal que podem ser compartilhada entre outras bactérias, por conjugação, como exemplo.

O que são fungos dimorficos?
São fungos que podem crescer tanto na forma de fungos filamentosos quanto na forma de leveduriformes. 
Sabendo que uma das famílias abaixo é um vírus de RNA (fita simples), com simetria icosaédrica, envelopado com glicoproteínas de superfície, famoso por conter a transcriptase reversa e sua transmissão é, principalmente, sexual?
a) Influenzavírus
b) Retrovírus
c) Arbovírus
d) Herpesvirus
b) Retrovírus

O que é damping off?
Doença fitopatogênica causado pelo fungo Rhizoctonia solani, que provoca o tombamento da planta.

Explique sucintamente por que na coloração de gram as bactérias gram-positivas são coradas em azul (púrpura) e as negativas em rosa.
As bactérias Gram-positivas são coradas em azul devido à aplicação do álcool que diminui a permeabilidade retendo o complexo cristal violeta-iodo dentro da célula bacteriana, gerando a colocação azul/roxo. Quanto a Gram-negativa, devido a sua membrana externa que recobre a parece celular, não são facilmente coradas, sendo estas posteriormente coradas pela fucsina.

Quanto aos fatores de patogenicidade, relacione as algumas características de exotoxinas e endotoxinas.
Exotoxinas: altamente toxica, liberadas por células vivas, encontrada em células tanto gram positivas quanto gram negativas, são exemplos de: tétano, botulismo e difteria.
Endotoxinas: encontrada apenas na parede celular de bactérias gram negativas, sua toxina possui constituição lipopolissacaridea (LPS).

Explique a frase “os esporos de fungos, entretanto, são completamente diferentes dos endosporos de bactérias”.
Os endosporos bacterianos permitem que as células sobrevivam a condições ambientais adversas, propagando a espécie sem duplicação da célula. Entretanto, após um fungo filamentoso formar um esporo, o mesmo se separa da célula parental e germina, originando um novo fungo filamentoso, sendo um mecanismo de reprodução.
Diferencie o ciclo lítico do lisogênico.

Um estudante de Ciências Biológicas estava passando pelo CCEN e percebeu uma planta com alguns aspectos causados por bactérias fitopatogenicas. Foi visível a formação de tumores e raízes no caule. A partir disso, qual bactéria é a provável causadora desses sintomas?
a) Pseudomonas spp
b) Erwinia spp
c) Xanthomonas spp
d) Ralstonia spp
e) Agrobacterium spp
e) Agrobacterium spp

O que são antibiogramas?
São testes laboratoriais que avaliam se a bactéria é sensível ou resistente a determinados tipos de antibióticos.
Descreve quais os mecanismos gerais de ação dos antibióticos e cite alguns exemplos.

Quais as principais estruturas que compõem as hifas reprodutivas de microfungos assexuados?
Conidioforo e conídios.

Quais as fases da biossíntese viral?

No gênero Erwinia, encontramos dois grupos distintos, as Pectolisticas e as Amylovora. Diferencie-as.
Pectoliticas: fungos que degradam pectina, provocando queima das ponteiras, sendo um sintoma exclusivo das bacterias pectoliticas;
Amylovora: fungos que degradam amido, provocando queimaduras, cancro e ate morte.